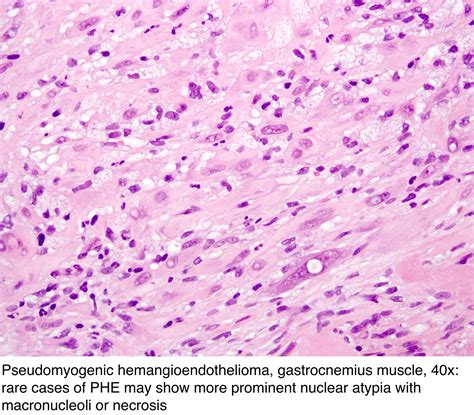

Eosinophilia In Malignancy: A Comprehensive Guide
Eosinophilia in Malignancy: A Comprehensive Guide
Hey guys! Ever heard of eosinophilia and its connection to malignancy ? Well, buckle up, because we’re about to dive deep into this fascinating and sometimes scary topic. We’ll explore what eosinophilia is, what it means when it pops up in the context of cancer, the different types of cancers associated with it, how doctors diagnose it, treatment options, and much more. It’s a complex subject, but I’ll break it down in a way that’s easy to understand. So, grab a coffee (or your beverage of choice), and let’s get started!
Table of Contents
- Understanding Eosinophilia
- The Role of Eosinophils
- Types of Eosinophilia
- Eosinophilia and Cancer: The Connection
- Cancers Associated with Eosinophilia
- The Impact on Cancer Treatment
- Diagnosing Eosinophilia in Malignancy
- Diagnostic Tools and Techniques
- Differential Diagnosis
- Treatment and Management
- Treatment Approaches
- Monitoring and Follow-up
- Prognosis and Outlook
- Factors Influencing Prognosis
- Long-Term Management
- Living with Eosinophilia and Malignancy
- Emotional and Psychological Support
- Practical Tips for Daily Life
- Resources and Support
Understanding Eosinophilia
So, what exactly is eosinophilia ? Simply put, it’s a condition where you have an abnormally high number of eosinophils in your blood. Eosinophils are a type of white blood cell, kind of like the body’s little defenders. Their main job is to fight off parasites, allergic reactions, and other inflammatory responses. Normally, the eosinophil count in your blood is pretty low, but when it spikes, that’s when you have eosinophilia. The normal range is typically less than 500 eosinophils per microliter of blood. Anything above that is considered eosinophilia, and the severity can range from mild to very serious, depending on the underlying cause. Now, there are various reasons why your eosinophil count might go up. Some common culprits include allergic reactions, asthma, parasitic infections, and certain medications. But, and this is a big but, it can also be a sign of something more serious, like cancer. When eosinophilia is linked to cancer, it’s called secondary eosinophilia . This is what we’re really focusing on today.
The Role of Eosinophils
Let’s talk a bit more about what eosinophils do. As mentioned, they’re part of your immune system. They release enzymes and other substances that help to kill parasites and break down inflammatory responses. Think of them as specialized little soldiers. They’re also involved in the inflammatory process, which is how your body responds to injury or infection. In the context of cancer, the role of eosinophils can be a bit complicated. Sometimes, they can help fight the cancer cells. Other times, they can actually promote tumor growth. This is still a really active area of research, and scientists are working hard to understand the exact role of eosinophils in different types of cancer. One thing is for sure: an elevated eosinophil count is often a red flag that something is going on in the body, and it’s a sign that doctors need to investigate further.
Types of Eosinophilia
There are broadly two types of eosinophilia: primary and secondary. Primary eosinophilia is when the eosinophils themselves are the problem, usually due to a bone marrow disorder. This is less common. Secondary eosinophilia , which we’re mainly concerned with, is when another condition causes the eosinophil count to rise. This can be allergies, infections, or, of course, cancer. Within secondary eosinophilia, the causes are varied, and the approach to finding the cause depends on the patient and the context. For instance, sometimes the eosinophilia is just a result of a medication the person is taking. Other times, it’s pointing to something like a parasitic infection. But when cancer is suspected, that’s a whole different ballgame. The goal of the doctor is to find out the underlying cause, and then choose an appropriate treatment plan. This can often involve a combination of methods, depending on the specific cause and the stage of the disease.
Eosinophilia and Cancer: The Connection
Alright, let’s get to the heart of the matter: the connection between eosinophilia and cancer . When you have cancer, your body can react in all sorts of ways. One of those reactions can be an increase in eosinophils. This happens because cancer cells can release substances that stimulate the production of eosinophils. These substances can also attract eosinophils to the tumor site. Sometimes, the eosinophils are there to try and fight the cancer. Other times, they may promote tumor growth or help the cancer spread. The exact mechanisms are still being studied, and they vary depending on the type of cancer. It’s important to understand that eosinophilia isn’t always a sign of cancer. But if you have it, and especially if it’s persistent or severe, your doctor will want to rule out cancer as a potential cause. Eosinophilia is often found in patients with specific types of cancer, like Hodgkin lymphoma and certain leukemias. This can sometimes be a clue that helps doctors find a diagnosis. Also, some research suggests that the presence of eosinophilia might be associated with a better prognosis in some types of cancer. But it’s complicated, and more research is needed to understand all of these relationships fully. So, if you’re experiencing eosinophilia, don’t panic, but do take it seriously. It’s something to investigate with your healthcare provider.
Cancers Associated with Eosinophilia
Several types of cancers are more frequently linked to eosinophilia . Hodgkin lymphoma is one of the most common culprits. In this type of cancer, the cancerous cells can release substances that trigger the production of eosinophils. Myeloproliferative neoplasms (MPNs) , a group of blood cancers, can also be associated with eosinophilia. These can include conditions like chronic myeloid leukemia and polycythemia vera. Gastrointestinal cancers , such as stomach, colon, and esophageal cancers, can sometimes be linked to eosinophilia. Additionally, certain types of lung cancer and ovarian cancer can also be associated with elevated eosinophil counts. The specific mechanisms vary depending on the cancer type. It can also vary from person to person. Because of this, the presence of eosinophilia is a clue for doctors. They will use this information, together with other diagnostic tools, to figure out what’s going on. It’s also important to note that just because you have eosinophilia doesn’t mean you automatically have cancer. But if you have the condition, your doctor will do the necessary tests to rule out any cancer or other underlying health issues.
The Impact on Cancer Treatment
Knowing about the presence of eosinophilia can influence how your cancer is treated. For example, if eosinophilia is found in a patient with Hodgkin lymphoma , it can sometimes be used as a marker to monitor the response to treatment. If the eosinophil count goes down after treatment, that can be a good sign that the cancer is responding. The presence or absence of eosinophilia might also help doctors assess the overall prognosis or likely outcome of the disease. In some cases, eosinophils might be targeted by therapies. This is still an area of active research. There is evidence that, in some situations, eosinophils can actually help fight cancer. But, they can also promote tumor growth, so the approach can depend on the specific cancer. One promising area of research is the development of immunotherapy treatments. These therapies aim to harness the power of the immune system to fight cancer. Understanding how eosinophils interact with the immune system could lead to better and more targeted cancer treatments in the future. The impact of eosinophilia on cancer treatment is a complex field. Doctors consider this information along with all the other factors of a patient’s case.
Diagnosing Eosinophilia in Malignancy
Okay, so how do doctors figure out if your eosinophilia is related to malignancy ? Well, it all starts with a blood test . This test is called a complete blood count (CBC), and it measures the different types of cells in your blood, including eosinophils. If the CBC shows a high eosinophil count, the doctor will want to investigate further. Next, the doctor will likely ask about your medical history. They’ll also ask about any symptoms you’re experiencing, like fever, weight loss, night sweats, or skin rashes. These are all clues that can help narrow down the possible causes. If cancer is suspected, the doctor will likely order additional tests. This might include a bone marrow biopsy, imaging scans (such as a CT scan or PET scan), and, potentially, a biopsy of any suspicious lumps or masses. The goal is to identify the underlying cause of the eosinophilia. The diagnosis will be based on a combination of these test results, the patient’s symptoms, and the overall clinical picture. It can take some time to get a definite diagnosis, but the doctor will guide you through the process.
Diagnostic Tools and Techniques
As mentioned, a complete blood count (CBC) is the first step in diagnosing eosinophilia . This simple blood test can reveal an elevated eosinophil count. If the count is high, the doctor will then order more tests to find the cause. Blood smear examination is usually done. This helps the doctor to check for any abnormal cells that could point to blood cancer. Further blood tests might include tests for allergy or parasitic infections. Imaging studies , like X-rays, CT scans, and MRI scans, are used to look for tumors or other abnormalities in the body. If a tumor is found, a biopsy may be done. This involves removing a small sample of tissue from the tumor so that it can be examined under a microscope. Bone marrow biopsy is crucial in the investigation. This test helps the doctors look for any problems with the production of blood cells. Each test provides different information that will ultimately guide diagnosis. The doctor will put all the pieces of the puzzle together to reach a proper diagnosis.
Differential Diagnosis
When a doctor sees eosinophilia , they need to consider all the possible causes, not just cancer . This is called a differential diagnosis. They’ll rule out other conditions like allergies, parasitic infections, drug reactions, and autoimmune diseases. It’s a careful process of elimination. Also, the doctor needs to know how long the eosinophilia has been present and if there are any other related symptoms. The medical history and a physical examination is essential in the diagnostic process. Sometimes, the eosinophilia is temporary and resolves on its own. In other cases, further investigation is needed. The goal is to arrive at the correct diagnosis. Then, the best treatment plan can be chosen. The differential diagnosis requires a thorough approach to get accurate results.
Treatment and Management
So, what happens if eosinophilia is linked to malignancy ? The treatment will depend on the type of cancer, the stage of the disease, and the overall health of the patient. In general, the goal of treatment is to eliminate the cancer. Cancer treatment options can include surgery, chemotherapy, radiation therapy, immunotherapy, and targeted therapy. If the eosinophilia is causing symptoms, such as an allergic reaction or inflammation, medications like corticosteroids may be used to control the symptoms. The treatment of the cancer itself will usually lead to a reduction in eosinophil counts. The treatment plan is personalized, and it’s created based on the specific situation of the patient. The doctor will work closely with the patient to determine the best course of action.
Treatment Approaches
The specific treatment for cancer-related eosinophilia depends on the type and stage of cancer. For Hodgkin lymphoma , chemotherapy is usually the primary treatment, often combined with radiation therapy. If the eosinophilia is severe, corticosteroids may be used to manage symptoms. For myeloproliferative neoplasms (MPNs) , treatments might include medications to control blood cell production, such as hydroxyurea, or targeted therapies. In the cases where surgery is an option, it may be used to remove tumors. Immunotherapy is a rapidly evolving treatment approach that can boost the immune system to fight cancer. It is also used to target eosinophils in some cancers, either to suppress them or to stimulate them. The treatment plan is complex. The doctor must also keep an eye on the side effects of treatment. The medical team will work together to support the patient during treatment and manage any complications.
Monitoring and Follow-up
After treatment, regular monitoring and follow-up are essential. This will help determine the efficacy of the treatment. It also helps to detect any recurrence of the cancer. Follow-up appointments usually involve physical examinations and blood tests, including CBCs to monitor eosinophil counts. Imaging scans may also be done periodically. The frequency of the follow-up depends on the type of cancer, the stage of the disease, and the treatment received. During these appointments, the patient will have a chance to discuss any symptoms or concerns with their doctor. If the eosinophil count remains high or increases after treatment, further investigation may be needed to determine if the cancer has returned or if there is another underlying cause.
Prognosis and Outlook
The prognosis , or outlook, for individuals with eosinophilia and malignancy varies widely. It depends on several factors, including the type and stage of cancer, how well the cancer responds to treatment, and the patient’s overall health. In general, the earlier the cancer is diagnosed and treated, the better the prognosis. The presence of eosinophilia may sometimes be a positive prognostic factor, especially in certain types of cancer. This could mean a better chance of response to treatment or longer survival. However, the connection is complex and varies among different cancers. There is also the patient’s age and overall health, which influence the prognosis. With advancements in cancer treatment, the outlook for many people with cancer is improving. It’s really important to talk to the healthcare team about the specific prognosis. The medical professionals will explain what to expect. They will provide information and support to manage the disease.
Factors Influencing Prognosis
Several factors can influence the prognosis of malignancy with eosinophilia . The type of cancer is a major factor. Some cancers are more aggressive and have a poorer prognosis than others. The stage of cancer at diagnosis plays a crucial role. Early-stage cancers are generally easier to treat and have a better prognosis than late-stage cancers. The patient’s overall health also affects the outcome. Patients with other health issues may have a harder time tolerating cancer treatments. The response to treatment is another important factor. If the cancer responds well to treatment, the prognosis is usually better. The presence of eosinophilia itself may sometimes be a factor. In some cases, high eosinophil counts are linked to a better prognosis. In other cases, it could mean that the cancer is more aggressive. It’s crucial to consider all the factors to understand the potential outlook.
Long-Term Management
Long-term management for individuals with eosinophilia and malignancy involves regular monitoring and follow-up care. This includes regular check-ups, blood tests, and imaging scans to watch for any signs of recurrence or side effects from treatment. Patients are advised to keep a healthy lifestyle. This includes a balanced diet, regular exercise, and avoiding smoking and excessive alcohol consumption. Managing the side effects of cancer treatment is also important. These may include fatigue, nausea, and other symptoms. The patient’s healthcare team will help manage these problems. Patients may be referred to support groups. This will help them cope with the physical and emotional challenges of living with cancer. The patient must have an open communication with their healthcare team. They will receive ongoing support and information to manage their health.
Living with Eosinophilia and Malignancy
Dealing with eosinophilia and malignancy can be really tough, both physically and emotionally. It’s important to remember that you’re not alone, and there are resources available to help you cope. Building a strong support system is key. This might include family, friends, support groups, and healthcare professionals. Talking about your feelings and sharing your experiences can make a big difference. It’s also important to take care of yourself. This means eating a healthy diet, getting regular exercise (if possible), getting enough sleep, and managing stress. Following your doctor’s recommendations for treatment and follow-up is also essential. Remember that there is hope. With advances in medical care, many people with cancer are living longer and better lives. So, keep up the fight, and lean on the resources available to you. You’ve got this!
Emotional and Psychological Support
Living with eosinophilia and malignancy is emotionally challenging. It’s completely normal to experience a range of emotions, including fear, anxiety, sadness, and anger. Seeking emotional and psychological support is crucial for your well-being. Talking to a therapist or counselor can help you process your feelings and develop coping strategies. Support groups provide an opportunity to connect with others who are going through similar experiences. Sharing your story and learning from others can be really validating. Family and friends can also provide support. You can explain what you are going through. Don’t hesitate to ask for help from them. Mindfulness and relaxation techniques can also help manage stress and anxiety. Remember, taking care of your mental health is just as important as taking care of your physical health.
Practical Tips for Daily Life
Living with eosinophilia and malignancy requires some adjustments to your daily life. It is important to prioritize your health. If you are going through treatment, you may need to plan your schedule. The patient may also need to rest more. Eating a healthy diet, rich in fruits, vegetables, and lean protein, can help support your body during treatment. Regular, gentle exercise, such as walking or yoga, can help boost your energy levels and mood (always check with your doctor before starting any new exercise routine). Make sure to follow your doctor’s instructions for medication and appointments. Ask for help when you need it. Let friends and family know how they can support you. It’s important to manage your energy and pace yourself. Remember, it’s okay to have good days and bad days. Allow yourself to rest when needed. Also, celebrate the small victories along the way.
Resources and Support
There are tons of resources and support systems available to help you navigate this journey. The American Cancer Society and the National Cancer Institute are great places to start. They offer information about cancer, treatment options, and support services. Cancer support groups are a fantastic way to connect with others who understand what you’re going through. You can find these groups online or through your hospital or cancer center. Your healthcare team is also a valuable resource. Ask them questions, share your concerns, and seek their guidance. Other organizations offer financial assistance to help with the costs of treatment and care. Don’t be afraid to ask for help. These resources can make a big difference in your quality of life. Accessing the support is not a sign of weakness but a sign of strength. It is a tool for coping.
That’s it, guys! We’ve covered a lot of ground today. Remember, if you have any concerns about eosinophilia or cancer, talk to your doctor. They’re the best ones to provide you with personalized advice and care. Stay strong, stay informed, and always remember to prioritize your health! If you want to know more about the subject, go see a doctor.